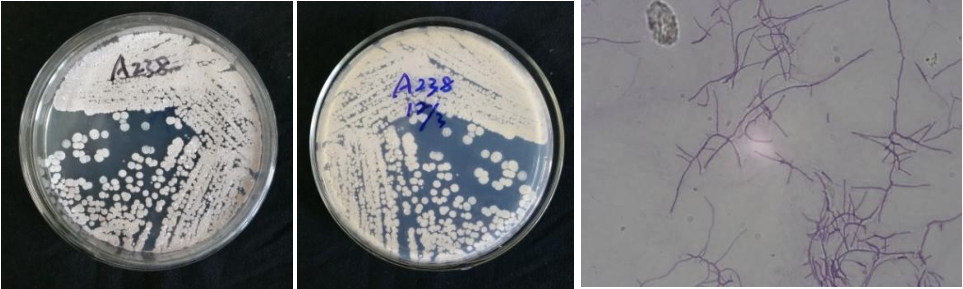

Loading...
| StrainNO | A238 |
| Classification | Amycolatopsis |
| 16s rDNA sequence | CACATGCAAGTCGAACGATGAAGCCTTCGGGTGGATTAGTGGCGAACGGGTGAGTAACACGTGGGTAATCTGCCCTGTACTCTGG GATAAGCCTTGGAAACGGGGTCTAATACCGGATATCACCGACTCTCGCATGGGGGTTGGTTGAAAGTTTCGGCGGTRCAGGATGA GCCCGCGGCCTATCAGCTTGTTGGTGGGGTGATGGCCTACCAAGGCGACGACGGGTAGCCGGCCTGAGAGGGTGACCGGCCACAC TGGGACTGAGACACGGCCCAGACTCCTACGGGAGGCAGCAGTGGGGAATATTGCACAATGGGCGGAAGCCTGATGCAGCGACGCC GCGTGAGGGATGACGGCCTTCGGGTTGTAAACCTCTTTCGCCAGGGACGAAGCGCAAGTGACGGTACCTGGATAAGAAGCACCGG CTAACTACGTGCCAGCAGCCGCGGTAATACGTAGGGTGCGAGCGTTGTCCGGATTTATTGGGCGTAAAGAGCTCGTAGGCGGTTT GTCGCGTCGTTCGTGAAAACTCCACGCTTAACGTGGAGCGTGCGGGCGATACGGGCAGACTTGAGTTCGGTAGGGGAGACTGGAA TTCCTGGTGTAGCGGTGAAATGCGCAGATATCAGGAGGAACACCGGTGGCGAAGGCGGGTCTCTGGGCCGATACTGACGCTGAGG AGCGAAAGCGTGGGGAGCGAACAGGATTAGATACCCTGGTAGTCCACGCTGTAAACGTTGGGCGCTAGGTGTGGGTGACATTCCA CGTTGTCCGTGCCGTAGCTAACGCATTAAGCGCCCCGCCTGGGGAGTACGGCCGCAAGGCTAAAACTCAAAGGAATTGACGGGGG CCCGCACAAGCGGCGGAGCATGTGGATTAATTCGATGCAACGCGAAGAACCTTACCTGGGCTTGACATGCACTGGAAACCAGTAG AGATATTGGCCCCCTTGTGGCCGGTGTACAGGTGGTGCATGGCTGTCGTCAGCTCGTGTCGTGAGATGTTGGGTTAAGTCCCGCA ACGAGCGCAACCCTTATCCTACGTTGCCAGCAAGTAAAGTTGGGGACTCGTGGGAGACTGCCGGGGTCAACTCGGAGGAAGGTGG GGATGACGTCAAGTCATCATGCCCCTTATGTCCAGGGCTTCACACATGCTACAATGGCTGGTACAGAGGGCTGCGATACCGCGAG GTGGAGCGAATCCCTTAAAGCCGGTCTCAGTTCGGATCGCAGTCTGCAACTCGACTGCGTGAAGTCGGAGTCGCTAGTAATCGCA GATCAGCAACGCTGCGGTGAATACGTTCCCGGGCCTTGTACACACCGCCCGTCACGTCATGAAAGTCGGTAACACCCGAAGCCCA TGGCCCAACCC |
| Strain Morphology Photos | |
| Morphological Description | Mycelia branch;there are septa not broken;there are bundles of filaments;individual old filaments have expanded part of spore filament spiral or curved;the spores are larger;long round spore pile milk |